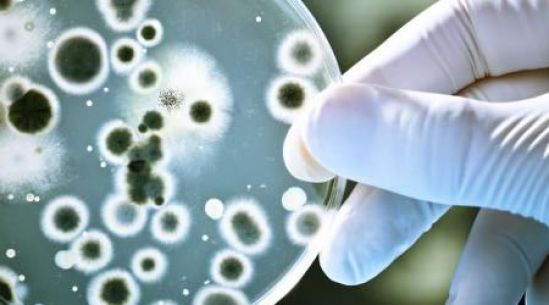
Proponen estudiantes de UVM nuevo antibiótico de un microorganismo, capaz de combatir Salmonella y Acinetobacter baumannii

Ambos microorganismos son considerados por la Organización Mundial de la Salud (OMS) como multidrogoresistentes, es decir, son resistentes a los fármacos de primera línea.
Fernanda y Leslie reportan estos resultados en la investigación Aislamiento y caracterización de un microorganismo productor de sustancias antagónicas frente a Salmonella y Acinetobacter baumannii multidrogoresistentes, y su objetivo es ofrecer una alternativa para encontrar moléculas antimicrobianas, que tengan la capacidad de hacer frente a patógenos multirresistentes.
Fernanda Cedeño Toscano expuso que tras tres años de investigación, encontraron un microorganismo a partir de muestras de masa nixtamalizada, mismo que tiene capacidad para producir compuestos antago´nicos según pudieron determinar. Gracias al uso de diferentes herramientas bioinforma´ticas, se definio´ que este microorganismo pertenece a la especie Alcaligenes faecalis, un microorganismo no patógeno.
Este presenta actividad antimicrobiana frente a las cepas ATCC BAA-007 y ATCC BAA-747 de Acinetobacter baumannii y cepas de Salmonella Typhimurium ATCC 14028 y ATCC 13311, además de la cepa ATCC 6539 de Salmonella Typhi.
Explicó que en el proceso que requiere la preparación de la masa, esta es sometida a condiciones de pH muy altas, por lo que la mayori´a de microorganismos muere, así que los pocos que logren sobrevivir es gracias a su versatilidad metabo´lica, y esta misma hace a los microorganismos capaces de producir sustancias antagónicas. Es por ello que proponen su uso como fuente de aislamiento de microorganismos antagónicos.
“Los antibióticos actuales ya no son efectivos para las enfermedades y debido al uso inadecuado de estos o a la automedicación, cada vez son menos eficaces”, dijo Leslie Morales.
La multidrogoresistencia representa uno de los principales problemas de salud a nivel mundial. En un comunicado publicado por la OMS en el año 2017, se estableció una lista de los patógenos prioritarios resistentes a los antibióticos, en la que se encuentran en nivel uno -de prioridad crítica- el Acinetobacter baumannii, un microorganismo causante de enfermedades nosocomiales -infecciones que se adquieren en hospitales por bacterias, virus, parásitos y hongos- y en prioridad media o nivel dos, Salmonella, la cual es responsable de diversas enfermedades gastrointestinales.
El proyecto se dividió en cuatro etapas, la primera fue el aislamiento de microorganismos, posteriormente se realizó la caracterización del microorganismo, las pruebas de actividad contra Salmonella y Acinetobacter baumannii, la extracción de los metabolitos secundarios producidos por Alcaligenes faecalis y finalmente su caracterización, ya que son los responsables de la actividad antimicrobiana.
Una vez caracterizado el microorganismo, llevaron a cabo pruebas con diferentes cepas de referencia de Salmonella Typhi, Tythimurium y Acinetobacter baumannii para analizar su espectro antimicrobiano.
En cajas Petri inocularon el microorganismo aislado, lo enfrentaron contra cepas de Salmonella y Acinetobacter, en este proceso observaron que hay halos de inhibición, lo que corrobora la susceptibilidad de los microorganismos hacia los metabolitos producidos por Alcaligenes faecalis.
Las estudiantes indicaron que están trabajando en una última fase que es la caracterización del compuesto, lo que significa realizar pruebas para identificar cual es la molécula responsable de la actividad antimicrobiana.
La investigación ha sido asesorada por el Dr. en C. Fernando Uriel Rojas Rojas, Dr. en C. Anuar Salazar Gómez, y de la Escuela Nacional de Ciencias Biológicas del IPN por la Dra. en C. Paulina Estrada de los Santos.
Redacción MD